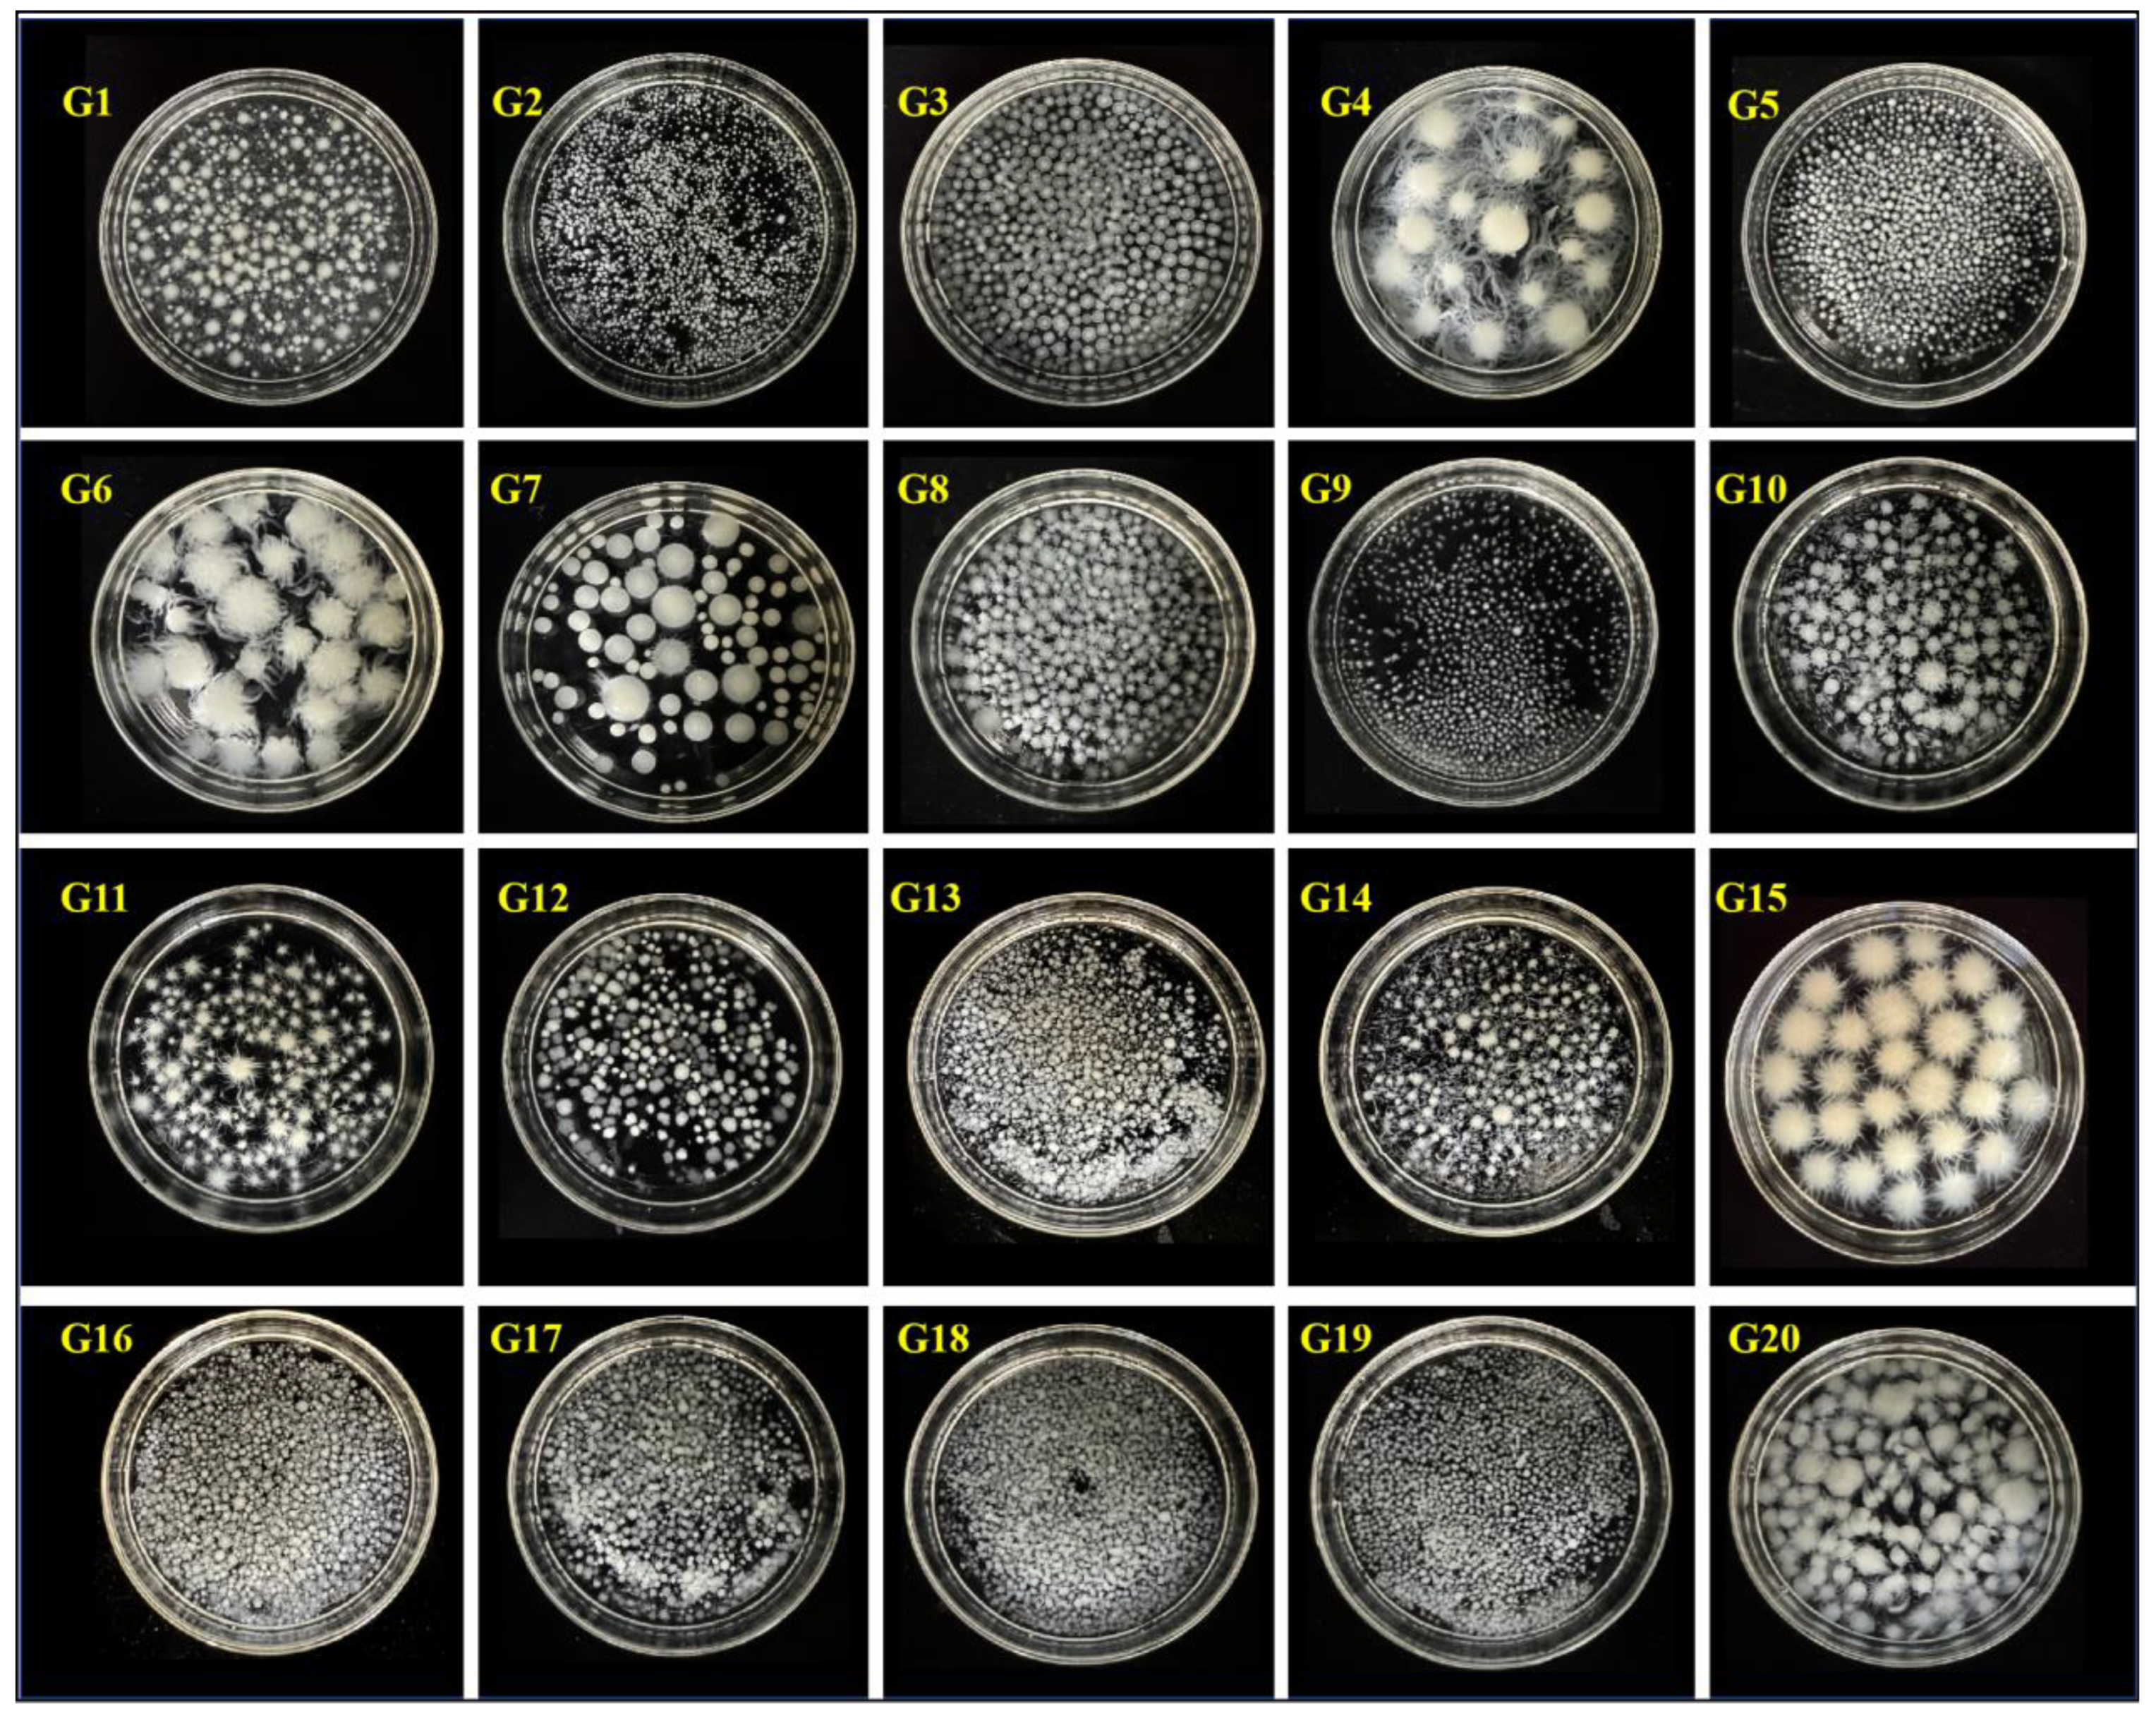
Jof 11 00326 g001

Revolutionizing Eco-Friendly Leather Production: A Freeze-Thaw and Liquid Fermentation Approach with Fungal Mycelium
Abstract
1. Introduction
2. Materials and Methods
2.1. Materials
2.2. Experimental Procedures
2.2.1. Seed Culture Preparation
2.2.2. Liquid Fermentation
2.2.3. Freeze-Thaw Dehydration
2.2.4. Post-Treatment
2.3. Characterisation
2.3.1. Mechanical Properties
2.3.2. Microstructure
2.3.3. Physical and Chemical Properties
2.3.4. Self-Healing Ability
2.3.5. Moisture Content and Dehydration Rate
3. Results and Discussion
3.1. Liquid Fermentation and Dehydration
3.1.1. Strain Screening
3.1.2. Impact of Freeze-Thaw Parameters
3.1.3. Mechanism of Freeze-Thaw Dehydration
3.2. Properties of Mycelial Membrane
3.2.1. Microstructural Analysis
3.2.2. Chemical Composition Analysis
3.2.3. Tensile Strength and True Density
3.2.4. Comparison with Alternative Methods
3.3. Properties of Fungal Mycelial Leather
3.3.1. Tensile Strength
3.3.2. AFM Analysis
3.3.3. Water Contact Angle Analysis
3.3.4. Self-Healing Capability Evaluation
3.3.5. Ashby Plot Analysis
4. Conclusions
Supplementary Materials
Author Contributions
Funding
Institutional Review Board Statement
Informed Consent Statement
Data Availability Statement
Conflicts of Interest
References
- Daddi, T.; Ahmad, S.; Albano, F. Fostering environmental sustainability of leather industry: Environmental impact assessment and improvement prospects for leather-tanning technologies. Environ. Sci. Pollut. Res. 2024, 32, 590. [Google Scholar] [CrossRef] [PubMed]
- Yang, F.; Zhang, Z.; Yuan, J.; Xu, J.; Ji, Q.; Bai, Y. Eco-friendly production of leather-like material from bacterial cellulose and waste resources. J. Clean. Prod. 2024, 476, 143700. [Google Scholar] [CrossRef]
- Wang, H. Advantages of animal leather over alternatives and its medical applications. Eur. Polym. J. 2024, 214, 113153. [Google Scholar] [CrossRef]
- Omoloso, O.; Mortimer, K.; Wise, W.R.; Jraisat, L. Sustainability research in the leather industry: A critical review of progress and opportunities for future research. J. Clean. Prod. 2021, 285, 125441. [Google Scholar] [CrossRef]
- Figueirôa, J.A.; Menezes Novaes, G.U.; de Souza Gomes, H.; de Morais Silva, V.L.M.; de Moraes Lucena, D.; Lima, L.M.R.; de Souza, S.A.; Viana, L.G.F.C.; Rolim, L.A.; da Silva Almeida, J.R.G.; et al. Opuntia ficus-indica is an excellent eco-friendly biosorbent for the removal of chromium in leather industry effluents. Heliyon 2021, 7, 07292. [Google Scholar] [CrossRef] [PubMed]
- Salazar Sandoval, S.; Amenábar, A.; Toledo, I.; Silva, N.; Contreras, P. Advances in the sustainable development of biobased materials using plant and animal waste as raw materials: A Review. Sustainability 2024, 16, 1073. [Google Scholar] [CrossRef]
- Muthukrishnan, L. Nanotechnology for cleaner leather production: A review. Environ. Chem. Lett. 2021, 19, 2527–2549. [Google Scholar] [CrossRef]
- Satish Kumar, Y.K. Economic Sustainability Analysis of Natural Leather Industry, and Its Alternative Advancements; Michigan Technological University: Houghton, MI, USA, 2021. [Google Scholar]
- Bettenhausen, C.A. Sustainable materials make a play for the leather market. CEN Glob. Enterp. 2021, 99, 23–24. [Google Scholar] [CrossRef]
- Ravindra, B.M.; Kiran, P.K.; Raju, K.C.; Himansu, B. Plant-based leather production: An update. World J. Adv. Eng. Technol. Sci. 2025, 14, 031–059. [Google Scholar] [CrossRef]
- Dhanda, V.; Arsalan, S.; Kaushal, S.; Shubham. Revolutionizing material: The rise of bio leather as eco- friendly and sustainable approach. Int. J. Agron. 2024, 7, 121–128. [Google Scholar] [CrossRef]
- Debora Lyn Porter, S.E.N. Hyphal systems and their effect on the mechanical properties of fungal sporocarps. Acta Biomater. 2022, 145, 272–282. [Google Scholar] [CrossRef] [PubMed]
- Jones, M.; Gandia, A.; John, S.; Bismarck, A. Leather-like material biofabrication using fungi. Nat. Sustain. 2020, 4, 9–16. [Google Scholar] [CrossRef]
- Liu, X.; Zhang, X.; Wang, X.; Yue, O.; Jiang, H. Engineered, environmentally friendly leather-like bio-based materials. Trends Biotechnol 2024, 37, 2598–2610. [Google Scholar] [CrossRef] [PubMed]
- Mascarin, G.M.; Golo, P.S.; de Souza Ribeiro-Silva, C.; Muniz, E.R.; de Oliveira Franco, A.; Kobori, N.N.; Fernandes, E.K.K. Advances in submerged liquid fermentation and formulation of entomopathogenic fungi. Appl. Microbiol. Biotechnol. 2024, 108, 451. [Google Scholar] [CrossRef]
- Shankar, M.P.; Hamza, A.; Khalad, A.; Shanthi, G.; Kuppireddy, S.; Kumar, D.S. Engineering mushroom mycelium for a greener built environment: Advancements in mycelium-based biocomposites and bioleather. Food Biosci. 2024, 62, 105577. [Google Scholar] [CrossRef]
- Yan, M.; Jiang, X.; Liu, Y.; Zhang, J.; Feng, J. Comprehensive evaluation of Ganoderma lucidum fermented grains: Nutritional, functional, and safety aspects. Food Biosci. 2025, 65, 106086. [Google Scholar] [CrossRef]
- Duré, L.M.M.; Mascarin, G.M.; Bettiol, W. Optimization of endospore production by solid and liquid fermentation for the development of effective formulations of Bacillus velezensis-based products. Braz. J. Microbiol. 2025, 56, 1–9. [Google Scholar] [CrossRef]
- Elsacker, E.; Vandelook, S.; Peeters, E. Recent technological innovations in mycelium materials as leather substitutes: A patent review. Front. Bioeng. Biotechnol. 2023, 11, 1204861. [Google Scholar] [CrossRef]
- Ross, P.; Wenner, N.; Moorleghen, C. Method of Producing Fungal Materials and Objects Made Therefrom. Google Patents EP20170828591, 14 July 2017. [Google Scholar]
- Williams, E.; Cenian, K.; Golsteijn, L.; Morris, B.; Scullin, M.L. Life cycle assessment of MycoWorks’ Reishi™: The first low-carbon and biodegradable alternative leather. Environ. Sci. Eur. 2022, 34, 120. [Google Scholar] [CrossRef]
- Liu, M.; Liu, L.; Zhang, G.; Wang, G.; Hou, R.; Zhang, Y.; Tian, X. Study on optimization of liquid fermentation medium and antitumor activity of the mycelium on phyllopora lonicerae. J. Microbiol. Biotechnol. 2024, 34, 1898–1911. [Google Scholar] [CrossRef]
- Attias, N.; Reid, M.; Mijowska, S.C.; Dobryden, I.; Isaksson, M.; Pokroy, B.; Grobman, Y.J.; Abitbol, T. Biofabrication of nanocellulose–mycelium hybrid materials. Adv. Sustain. Syst. 2021, 5, 2000196. [Google Scholar] [CrossRef]
- Kniep, J.; Graupner, N.; Reimer, J.J.; Müssig, J. Mycelium-based biomimetic composite structures as a sustainable leather alternative. Mater. Today Commun. 2024, 39, 109100. [Google Scholar] [CrossRef]
- Biront, A.; Sillen, M.; Van Dijck, P.; Wurm, J. Growth propagation of liquid spawn on non-woven hemp mats to inform digital biofabrication of mycelium-based composites. Biomimetics 2025, 10, 33. [Google Scholar] [CrossRef]
- Merivaara, A.; Zini, J.; Koivunotko, E.; Valkonen, S.; Korhonen, O.; Fernandes, F.M.; Yliperttula, M. Preservation of biomaterials and cells by freeze-drying: Change of paradigm. J. Control. Release 2021, 336, 480–498. [Google Scholar] [CrossRef] [PubMed]
- Rathinamoorthy, R.; Sharmila Bharathi, T.; Snehaa, M.; Swetha, C. Mycelium as sustainable textile material–review on recent research and future prospective. Int. J. Cloth. Sci. Technol. 2023, 35, 454–476. [Google Scholar] [CrossRef]
- Chang, T.; Zhao, G. Ice inhibition for cryopreservation: Materials, strategies, and challenges. Adv. Sci. News 2021, 8, 2002425. [Google Scholar] [CrossRef]
- Zhao, Y.; Yan, M.; Xue, S.; Zhang, T.; Shen, X. Influence of ultrasound and enzymatic cross-linking on freeze-thaw stability and release properties of whey protein isolate hydrogel. J. Dairy Sci. 2022, 105, 7253–7265. [Google Scholar] [CrossRef]
- Bucak, C.D. Porous alginate hydrogel beads cross-linked with citric acid containing tannic acid: Structural analysis, antimicrobial properties and release behavior. Cellulose 2023, 30, 1117–1132. [Google Scholar] [CrossRef]
- He, Y.; Ye, H.; Li, H.; Cui, F.; Xu, F.; You, T. Multifunctional films with superior mechanical performance, transparency, antibacterial properties enabled by a physical and chemical dual crosslinking network construction. Chem. Eng. J. 2024, 479, 147546. [Google Scholar] [CrossRef]
- GB/T 38610-2020; Electric Clothes Washer-Dryers for Household Use—Methods for Measuring the Performance. National Standard of the People’s Republic of China: Beijing, China, 2020.
- Zhang, M.; Zhang, Z.; Zhang, R.; Peng, Y.; Wang, M.; Cao, J. Lightweight, thermal insulation, hydrophobic mycelium composites with hierarchical porous structure: Design, manufacture and applications. Compos. Part B Eng. 2023, 266, 111003. [Google Scholar] [CrossRef]
- Elsacker, E.; Zhang, M.; Dade-Robertson, M. Fungal engineered living materials: The viability of pure mycelium materials with self-healing functionalities. Adv. Funct. Mater. 2023, 33, 2301875. [Google Scholar] [CrossRef]
- Huo, Y.; Yang, D.; Xie, J.; Yang, Z. Effect of different freezing conditions on ice crystal formation behavior and ice-growth inhibition by cryoprotectants. J. Sci. Food Agric. 2024, 104, 8928–8938. [Google Scholar] [CrossRef] [PubMed]
- Zheng, O.; Zhang, L.; Sun, Q.; Liu, S. Basic theory of ice crystallization based on water molecular structure and ice structure. Foods 2024, 13, 2773. [Google Scholar] [CrossRef] [PubMed]
- Tan, M.; Mei, J.; Xie, J. The formation and control of ice crystal and its impact on the quality of frozen aquatic products: A review. Crystals 2021, 11, 68. [Google Scholar] [CrossRef]
- Shao, G.; Xu, D.; Xu, Z.; Jin, Y.; Wu, F.; Yang, N.; Xu, X. Green and sustainable biomaterials: Edible bioplastic films from mushroom mycelium. Food Hydrocoll. 2024, 146, 109289. [Google Scholar] [CrossRef]
- Sun, C.; Wang, Z.; Chen, L.; Li, F. Fabrication of robust and compressive chitin and graphene oxide sponges for removal of microplastics with different functional groups. Chem. Eng. J. 2020, 393, 124796. [Google Scholar] [CrossRef]
- Sun, W.; Tajvidi, M.; Hunt, C.G.; Howell, C. All-Natural Smart Mycelium Surface with Tunable Wettability. ACS Appl. Bio Mater. 2020, 4, 1015–1022. [Google Scholar] [CrossRef]
- Bustillos, J.; Loganathan, A.; Agrawal, R.; Gonzalez, B.A.; Perez, M.G.; Ramaswamy, S.; Boesl, B.; Agarwal, A. Uncovering the mechanical, thermal, and chemical characteristics of biodegradable mushroom leather with intrinsic antifungal and antibacterial properties. ACS Appl. Bio Mater. 2020, 3, 3145–3156. [Google Scholar] [CrossRef]
- Zhang, X.; Hu, J.; Fan, X.; Yu, X. Naturally grown mycelium-composite as sustainable building insulation materials. J. Clean. Prod. 2022, 342, 130784. [Google Scholar] [CrossRef]
- Le, T.M.; Tran, C.L.; Nguyen, T.X.; Duong, Y.H.P.; Le, P.K.; Tran, V.T. Green Preparation of Chitin and Nanochitin from Black Soldier Fly for Production of Biodegradable Packaging Material. J. Polym. Environ. 2023, 31, 3094–3105. [Google Scholar] [CrossRef]
- Bucinell, R.B.; Keever, R.; Tudryn, G. A novel tensile specimen configuration for the characterization of bulk mycelium biopolymer. Exp. Tech. 2019, 44, 249–258. [Google Scholar] [CrossRef]
- Ma, X.; Lin, X.; Chang, C.; Duan, B. Chitinous bioplastic enabled by noncovalent assembly. ACS Nano 2024, 18, 8906–8918. [Google Scholar] [CrossRef] [PubMed]
- Liu, Q.; Li, Y.; Xing, S.; Wang, L.; Yang, X.; Hao, F.; Liu, M. Genipin-crosslinked amphiphilic chitosan films for the preservation of strawberry. Int. J. Biol. Macromol. 2022, 213, 804–813. [Google Scholar] [CrossRef]
- Deeg, K.; Gima, Z.; Audrey, S.; Oana, S.; Kathy, T. Greener Solutions: Improving Performance of Mycelium-Based Leather; Semantic Scholar: 2017. Available online: https://bcgc.berkeley.edu/sites/default/files/gs_2017_mycoworks_finalreport.pdf (accessed on 15 April 2025).
- Greer, J.R.; Deshpande, V.S. Three-dimensional architected materials and structures: Design, fabrication, and mechanical behavior. MRS Bull. 2019, 44, 750–757. [Google Scholar] [CrossRef]

Disclaimer/Publisher’s Note: The statements, opinions and data contained in all publications are solely those of the individual author(s) and contributor(s) and not of MDPI and/or the editor(s). MDPI and/or the editor(s) disclaim responsibility for any injury to people or property resulting from any ideas, methods, instructions or products referred to in the content. |
© 2025 by the authors. Licensee MDPI, Basel, Switzerland. This article is an open access article distributed under the terms and conditions of the Creative Commons Attribution (CC BY) license (https://creativecommons.org/licenses/by/4.0/).
Share and Cite
Song, L.; Liu, Y.; Xiao, S.; Yuan, X.; Han, X. Revolutionizing Eco-Friendly Leather Production: A Freeze-Thaw and Liquid Fermentation Approach with Fungal Mycelium. J. Fungi 2025, 11, 326. https://doi.org/10.3390/jof11040326
Song L, Liu Y, Xiao S, Yuan X, Han X. Revolutionizing Eco-Friendly Leather Production: A Freeze-Thaw and Liquid Fermentation Approach with Fungal Mycelium. Journal of Fungi. 2025; 11(4):326. https://doi.org/10.3390/jof11040326
Chicago/Turabian StyleSong, Linxin, Yuxin Liu, Shijun Xiao, Xiaohui Yuan, and Xuerong Han. 2025. "Revolutionizing Eco-Friendly Leather Production: A Freeze-Thaw and Liquid Fermentation Approach with Fungal Mycelium" Journal of Fungi 11, no. 4: 326. https://doi.org/10.3390/jof11040326
APA StyleSong, L., Liu, Y., Xiao, S., Yuan, X., & Han, X. (2025). Revolutionizing Eco-Friendly Leather Production: A Freeze-Thaw and Liquid Fermentation Approach with Fungal Mycelium. Journal of Fungi, 11(4), 326. https://doi.org/10.3390/jof11040326

